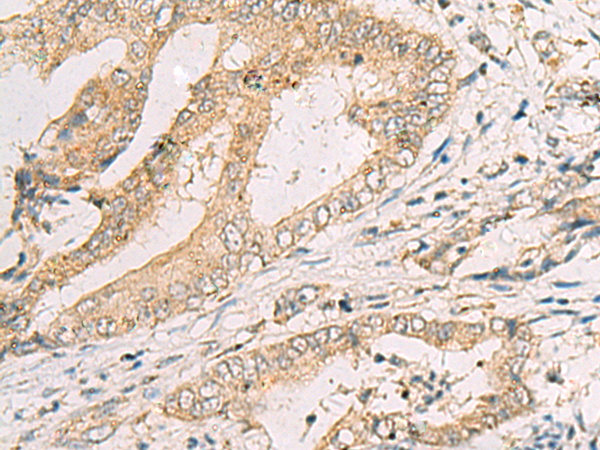

|
Background: |
The correlation of anti-sperm antibodies with cases of unexplained infertility implicates a role for these antibodies in blocking fertilization. Improved diagnosis and treatment of immunologic infertility, as well as identification of proteins for targeted contraception, are dependent on the identification and characterization of relevant sperm antigens. The protein expressed by this gene is recognized by anti-sperm antibodies from infertile males. Furthermore, antibodies generated against the recombinant protein block in vitro fertilization. This protein localizes to the acrosomal membrane of spermatids and mature spermatozoa where it is thought to play a role in acrosomal morphogenesis and in sperm-egg binding and fusion, respectively. |
|
Applications: |
ELISA, IHC |
|
Name of antibody: |
SPACA1 |
|
Immunogen: |
Fusion protein of human SPACA1 |
|
Full name: |
sperm acrosome associated 1 |
|
Synonyms: |
SAMP32 |
|
SwissProt: |
Q9HBV2 |
|
ELISA Recommended dilution: |
5000-10000 |
|
IHC positive control: |
Human cervical cancer and Human colorectal cancer |
|
IHC Recommend dilution: |
50-100 |

購(gòu)物車(chē)
購(gòu)物車(chē) 幫助
幫助
 021-54845833/15800441009
021-54845833/15800441009
